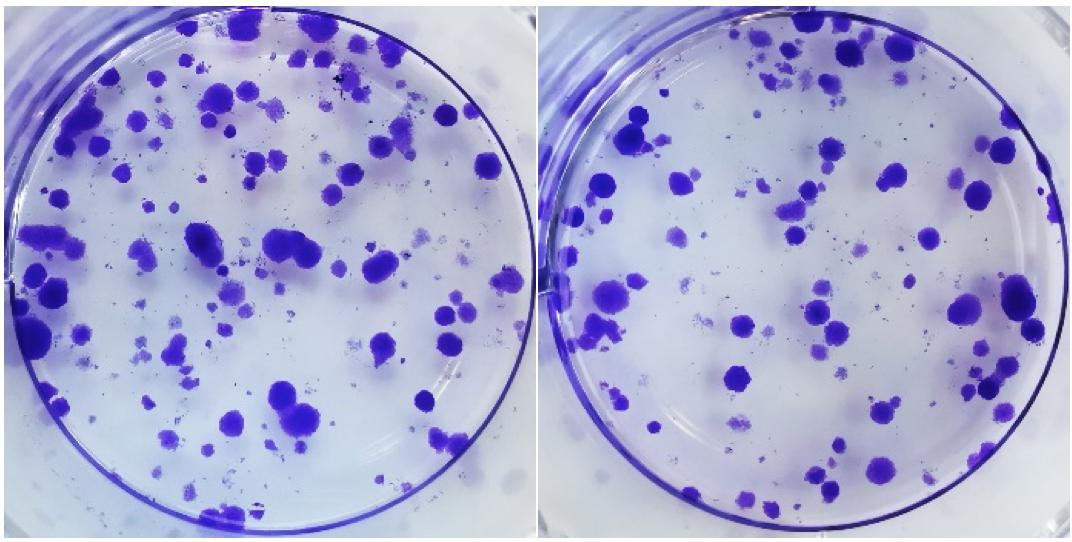
细胞克隆形成

万千商家帮你免费找货
0 人在求购买到急需产品
- 详细信息
- 文献和实验
- 技术资料
- 服务名称:
细胞克隆形成
- 提供商:
XSL
细胞克隆形成率即细胞接种存活率,表示接种细胞后贴壁的细胞成活并形成克隆的数量。贴壁后的细胞不一定每个都能增殖和形成克隆,而形成克隆的细胞必为贴壁和有增殖活力的细胞。克隆形成率反映细胞群体依赖性和增殖能力两个重要性状。
基本步骤
1.取对数生长期的各组细胞,分别用0.25%胰蛋白酶消化并吹打成单个细胞,并把细胞悬浮在10%胎牛血清的DMEM培养液中备用。
2.将细胞悬液作梯度倍数稀释,每组细胞分别以每皿50、100、200个细胞的梯度密度分别接种含10mL 37℃预温培养液的皿中,并轻轻转动,使细胞分散均匀。置37℃ 5% CO2及饱和湿度的细胞培养箱中培养2~3周。
3.经常观察,当培养皿中出现肉眼可见的克隆时,终止培养。弃去上清液,用PBS小心浸洗2次。加4%多聚贾醛固定细胞 5mL固定15分钟。然后去固定液,加适量GIMSA应用染色液染10~30分钟,然后用流水缓慢洗去染色液,空气干燥。
4.将平皿倒置并叠加一张带网格的透明胶片,用肉眼直接计数克隆,或在显微镜(低倍镜)计数大于10个细胞的克隆数。最后计算克隆形成率。克隆形成率 =(克隆数/接种细胞数)×100% 平板克隆形成试验方法简单,适用于贴壁生长的细胞。适宜底物为玻璃的、塑料瓶皿。试验成功的关键是细胞悬液的制备和接种密度。细胞一定要分散得好,不能有细胞团,接种密度不能过大。
5.服务周期 1-2个月
收费标准/服务周期/提供结果:
欢迎咨询详谈,我们会根据您的方案及需求制定详细的服务协议。
更多实验技术服务请浏览网站其他内容,或来电咨询!
风险提示:丁香通仅作为第三方平台,为商家信息发布提供平台空间。用户咨询产品时请注意保护个人信息及财产安全,合理判断,谨慎选购商品,商家和用户对交易行为负责。对于医疗器械类产品,请先查证核实企业经营资质和医疗器械产品注册证情况。
文献和实验概念: 细胞克隆形成率即细胞接种存活率,表示接种细胞后贴壁的细胞成活并形成克隆的数量。贴壁后的细胞不一定每个都能增殖和形成克隆,而形成克隆的细胞必为贴壁和有增殖活力的细胞。克隆形成率反映细胞群体依赖性和增殖能力两个重要性状。 基本步骤: 1、取对数生长期的各组细胞,分别用0.25%胰蛋白酶消化并吹打成单个细胞,并把细胞悬浮在10%胎牛血清的DMEM培养液中备用。 2、将细胞悬液作梯度倍数稀释,每组细胞分别以每皿50、100、200个细胞的梯度密度分别接种含10mL 37℃预温
在担子菌纲的次生菌丝,即通过初生菌丝的体细胞接合产生的双核菌丝中特殊的细胞分裂和核分裂形式。其结构如下图所示。把由于分裂而形成的小突起称作“钳伏突起”( clamp),把对核同时进行的分裂(图 4)称作偶联核分裂( conjugate divisi-on)。此外,把产生在二子细胞间的这种特殊结构称作“钳状连结”( clamp connection)。钳状形成是随着细胞质融合和核融合在时间上和位置上都分开的所出现的担子菌类特有的现象。次生菌丝的细胞分别具有单倍体( n)的异型核,称为双倍
管型是尿沉渣中有重要意义的成分,管型尿的出现往往提示有肾实质性损害。 管型尿是尿液中的蛋白质在肾小管、集合管内凝固而形成的圆柱状结构物,管型的形成必需有蛋白尿,其形成基质物为T-H糖蛋白。在病理情况下,由于肾小球基底膜的通透性增加,大量蛋白质由肾小球进入肾小管,在肾远曲小管和集合管内,由于浓缩(水分吸收)酸化(酸性物增加)和软骨素硫酸酯的存在,蛋白质在肾小管腔内凝聚、沉淀,形成管型。 管型尿是由于蛋白质在肾小管内凝固。管型尿的形成与尿蛋白的性质、浓度、尿液酸碱
技术资料暂无技术资料 索取技术资料









